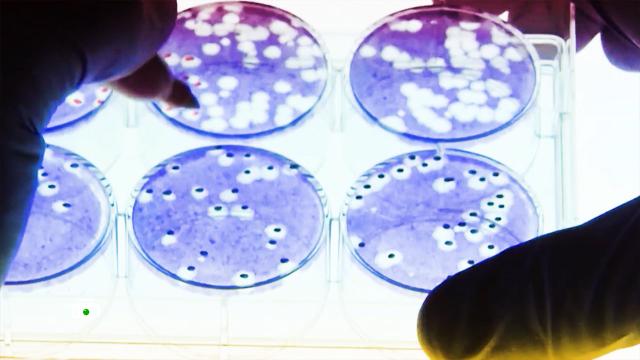

Минобороны в ходе проведения спецоперации обнаружило документы, доказывающие, что на Украине проводились опыты с бактериями чумы, холеры, сибирской язвы и другими сложными патогенами. В найденных документах говорилось об экстренном их уничтожении, а датированы они днем, когда на Украине началась спецоперация ВС России. Биолаборатории финансировались США.
Замгоссекретаря США по политическим вопросам Виктория Нуланд подтвердила, что на Украине действительно есть такие лаборатории. При этом она отметила, что Америка и Украина сейчас работают над тем, чтобы предотвратить переход любых исследовательских материалов в руки российских войск.
Этот ответ Нуланд ошарашил в первую очередь самих американцев.
Такер Карлсон, ведущий Fox News: «У нас челюсти отвисли. Под присягой на открытых слушаниях Нуланд только что подтвердила, что российская „дезинформация“, которую они несколько дней клеймили аморальной ложью и безумной теорией заговора, оказалась правдой от начала до конца».
Ответ на вопрос, зачем военные биолаборатории нужны в 25 странах мира, пыталась найти болгарская журналистка Диляна Гайтанджиева.
Диляна Гайтанджиева, журналист: «Согласно документам, которые я получила из базы данных федеральной контрактной системы США, Пентагон потратил 2,5 млрд долларов на проведение исследований в биолабораториях по всему миру. Почему Пентагон тратит такую огромную сумму денег на здоровье иностранных граждан, а не своих собственных?»
Тем более, что здоровье граждан, живущих в тех местах, где располагались эти лаборатории, скорее, пошатнулось. К примеру, в Грузии начали отмечать необъяснимые локальные вспышки экзотических инфекций. От вируса
Безопасностью и сутью работы полутора десятков этих лабораторий не один раз интересовались депутаты Верховной Рады Украины. Они отправляли запросы и на имя президента Владимира Зеленского и даже в ООН.
Ренат Кузьмин, депутат Верховной рады: «Мы заставили украинскую власть через судебное решение возбудить три уголовных дела по фактам функционирования этих биолабораторий и заражения людей в районах дислокации этих биолабораторий. Мы хотим узнать правду: чем эти биолаборатории занимаются?»
Все эти годы ответ был один — исследовательские работы по предотвращению распространения смертельных болезней. Таких полуместных, полуамериканских лабораторий по периметру границ России за последние годы появились десятки. Агентство Reuters получило комментарий от Всемирной организации здравоохранения, которая утверждает, что тоже настойчиво рекомендовала Украине уничтожить высокоопасные патогены.
Подозрения эта деятельность вызывала всегда. Еще в 2018 году в авторитетном американском научном журнале Science вышла статья под заголовком «Сельскохозяйственные исследования или новая система биооружия?» Авторы выражали сомнения, что Агентство перспективных оборонных исследовательских проектов, которое курирует все эти лаборатории, ограничиваются мирными целями.
Программу можно рассматривать как попытку разработать биологические агенты для враждебных целей и средств их доставки, что являлось бы нарушением Конвенции о биологическом оружии. Именно так это и рассматривают в Минобороны России. В ведомстве также указывают на то, что участники совместных
Скотт Беннет, бывший офицер армии США: «То есть это оружие было бы нацелено на славянскую ДНК, по сути, на системы, на органы, на общий жизненный цикл человека в географических регионах России и Восточной Европы. Да, это звучит как фантастика, и никто не знает, возможно ли это с практической точки зрения, но США всегда действуют с позиций — почему бы не попробовать?»
Пробовали и пробуют, возможно, по многим направлениям, в том числе и в области изучения способов доставки опасных вирусов. В материалах из биолабораторий есть упоминания и о летучих мышах, и о насекомых, и о птицах.
В Минобороны утверждают, что в апреле прошлого года в Ивановской и Воронежской областях были отловлены окольцованные птицы, выпущенные в ходе биологических исследований из Херсонского заповедника на Украине. Российские силовики считают это подтверждением того, что биологи из украинских лабораторий изучали возможность использования как переносчиков особо опасных инфекций перелетных птиц, чьи маршруты проходят через территорию России.